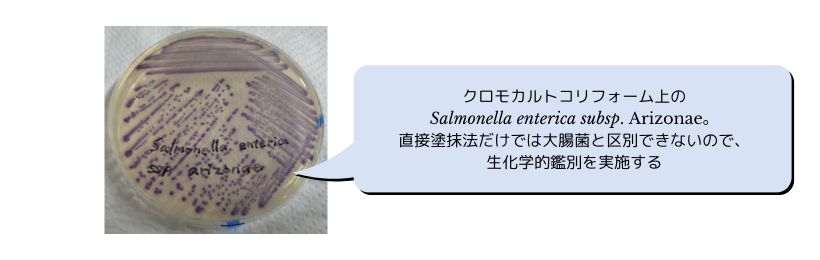

【培地】酵素基質培地とは?|畜産検査分野での利用
酵素基質培地とは、『標的とする微生物が特異的に産生する基質に発色(もしくは発光)する物質を標識した特異酵素基質を含ませた培地』です。70年代に発明された酵素基質培地ですが、それまでのpH等を利用した選択培地と異なり、客観的に判定がしやすいと言われています。標的以外の菌や夾雑物の影響を受けにくいため、畜産分野の検体である家畜糞便や堆肥など菌の種類や数が多いものの検査でも重宝します。
しかし、従来の培地と検出方法が違うということは当然少なからず「ズレ」が生じてしまうということも、検査に当たって頭の片隅に入れなくてはなりません。
例えば大腸菌群の場合、定義により「ラクトースを分解してガスを産生する」という性質が大前提としてあります。従来の選択培地であるデソキシコレート寒天培地はこの性質を利用した培地です。対して大腸菌群をターゲットとした酵素基質培地は大腸菌群がβ-ガラクトシダーゼという酵素を持っていることを利用している培地です。β-ガラクトシダーゼを指標とした場合、乳糖非分解のビブリオ属の一部の菌や遅分解のD群赤痢菌など定義から外れるはずの菌も追加されるため陽性率は高くなります。
また、大腸菌を酵素基質培地で検出するとなると、上記に加えβ-グルクロニダーゼを指標とした発色基質を加えますが、大腸菌のβ-グルクロニダーゼ保有率は95%前後と言われています。大腸菌も100%検出できるわけではない上に、β-ガラクトシダーゼ活性陽性且つβ-グルクロニダーゼ活性陽性の菌は、この判定方法のみでは鑑別ができないのです。
ISOにおいては『β-グルクロニダーゼ陽性大腸菌をカウントするための水平法』という検査方法も提示されており、一部の国では発色酵素基質培地を用いた測定法が公定法として、定められています。
国際化の流れを受け、わが国においても公定法として取り入れられる可能性も否定できませんので、市販培地の原理を理解するということは重要ですし、検査手技の応用も可能となります。
>>畜産検査・コンサルページはこちら